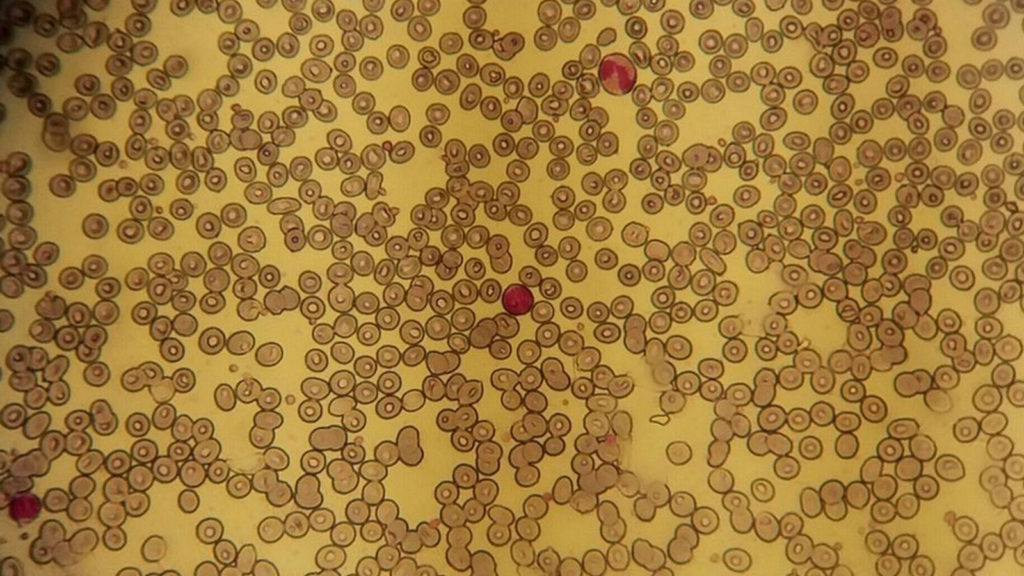

LUCA (Last Universal Common Ancestor) es el organismo hipotético que se cree que es el antepasado común de todos los organismos vivos actuales en la Tierra. Se cree que LUCA vivió hace aproximadamente 3.500 millones de años. Aunque no se sabe con certeza cómo era LUCA, se cree que era un organismo unicelular, procarionte (sin núcleo definido) y que se alimentaba mediante fermentación o fotosíntesis. La existencia de LUCA se ha inferido a través del estudio de la evolución molecular y la comparación de los genomas de diferentes organismos vivos.
En términos Géologicos la vida de organismos como LUCA ocurrió muy temprano en el desarrollo del planeta en la edad Precambrica, la primera de los Supereones que compone las eras del planeta. LUCA fue capaz de adaptarse, sobrevivir y prosperar en condiciones en extremo adversas y cambiantes en un planeta de clima y tectónica bastante hostil
Las edades geológicas de la tierra
La historia geológica de la Tierra se divide en varias edades, cada una de las cuales representa un período de tiempo durante el cual se producen cambios significativos en la corteza terrestre y en la vida que habita en ella. La vida ha sabido adaptarse a las condiciones de cada una de estas edades y eras. El planeta temprano era un lugar muy diferente a la tierra que conocemos hoy.
La atmosfera hubiera resultado imposible de respirar, las concentraciones de oxigeno eran bajas y gases venenosos para la vida a base de carbono componían el aire saturado de ceniza volcánica. Las temperaturas podían variar en extremo, desde eras glaciares, hasta veranos en extremo calurosos.
La misma tectónica de placas era muy diferente, un solo océano y un solo continente creaban climas extremos y tormentas como jamás hemos experimentado los humanos. Las grandes extensiones de tierra creaban desiertos de calores y fríos extremos dónde poquísimos organismos podían sobrevivir.
La vida inició en el agua dónde podía apegarse a condiciones apenas un poco más estables y sin embargo dependía de luz solar para realizar procesos fotosintéticos y poder alimentarse y realizar sus procesos vitales.
El Precambrico y el Arcaíco.



El período precámbrico es el período más antiguo de la historia geológica de la Tierra, que abarca desde el inicio de la Tierra hace unos 4.500 millones de años hasta el final de la era Arcaica hace unos 541 millones de años. Durante este período, se formó la corteza terrestre, se produjo la primera aparición de vida, y se desarrollaron los océanos y los continentes.
En los primeros millones de años después de la formación de la Tierra, el planeta estaba cubierto de rocas fundidas y magma, y el clima era muy caliente debido a la gran cantidad de radiación solar que recibía. Con el tiempo, la corteza terrestre se enfrió y solidificó, y los océanos se formaron a medida que el agua del interior del planeta se filtraba a través de las fisuras de la corteza.
En la era Arcaica, se produjo la primera aparición de vida en la Tierra. Los científicos creen que la vida se originó en los océanos, en forma de microorganismos simples como bacterias y algas. Estos organismos se desarrollaron para sobrevivir en un ambiente hostil, y se adaptaron para realizar funciones biológicas esenciales como la fotosíntesis y la fermentación.
A medida que la vida se desarrollaba, los océanos se llenaban de vida, y los continentes se formaban a medida que las placas tectónicas se movían. Los primeros continentes eran pequeños y estaban cubiertos de rocas ígneas y metamórficas. Con el tiempo, los continentes se expandieron y se formaron grandes cordilleras, y los océanos se volvieron más profundos.
En el período precámbrico no existían los organismos complejos como los invertebrados y los vertebrados, y la vida se limitaba a microorganismos unicelulares. Sin embargo, este período es crucial para entender la historia de la vida en la Tierra, ya que fue durante este tiempo cuando se produjo la primera aparición de vida, y se desarrollaron las funciones biológicas esenciales que permitieron la evolución de organismos más complejos.
Eucariotas, procariotas y extremófilos.
Existen 2 tipos de células aquellas con núcleo y aquellas sin él. Las células con núcleo concentran y centralizan en él sus procesos vítales a manera de un punto de control o cerebro celular y son aquellas células que son capaces de organizarse en tejidos, órganos y organismos más complejos. Las células procariotas son aún más simples que las Eucariotas y no tienen núcleo, lo único que las separa del entorno es la barrera o pared celular. Abajo encontrarás una explicación más detallada de cada tipo de célula y de una subdivisión de ambas llamados extremófilos.
Procariotas
Las células procariotas son un tipo de célula que no tiene un núcleo bien definido y sus cromosomas se encuentran dispersos en el citoplasma. Estas células son generalmente pequeñas, con tamaños que van desde 0,5 a 5 micrómetros de diámetro, y pueden ser unicelulares o formar colonias. Los procariotas son organismos muy diversos y pueden ser encontrados en prácticamente todos los ambientes en la Tierra, desde el agua hasta el suelo y el cuerpo humano.
Existen dos tipos principales de procariotas: bacterias y arqueas. Las bacterias son los procariotas más comunes y pueden ser encontradas en prácticamente todos los ambientes. Pueden ser aerobias (necesitan oxígeno para vivir) o anaerobias (no necesitan oxígeno para vivir) y algunas son patógenas y causan enfermedades en los seres humanos, mientras que otras son benéficas y desempeñan un papel importante en la digestión y la descomposición de la materia orgánica.



Eucariotas
Las células eucariotas son un tipo de célula que tienen un núcleo bien definido y sus cromosomas están rodeados por una membrana nuclear. Estas células también tienen un citoesqueleto y organelos membranosos que les permiten realizar funciones específicas. Los organelos más comunes en las células eucariotas incluyen el núcleo, la mitocondria, el retículo endoplásmico, el aparato de Golgi y los cloroplastos (en las células vegetales).
Las células eucariotas son generalmente más grandes que las células procariotas, con tamaños que van desde 10 a 100 micrómetros de diámetro. Los organismos que tienen células eucariotas incluyen plantas, animales, hongos y protistas.
Los organismos eucariotas son muy variados y pueden ser unicelulares o pluricelulares. Los organismos unicelulares eucariotas incluyen las amebas y las algas, mientras que los organismos pluricelulares incluyen las plantas, los animales y los hongos. Los organismos eucariotas también pueden ser heterótrofos (dependen de otros organismos para obtener su alimento) o autótrofos (pueden producir su propio alimento mediante la fotosíntesis).

Extremófilos
Los extremófilos son organismos capaces de sobrevivir y prosperar en ambientes extremos, como temperaturas extremadamente altas o bajas, altas presiones, altas concentraciones de sal o radiación. Los extremófilos son generalmente procariotas, aunque también pueden ser eucariotas. Los extremófilos son importantes porque nos ayudan a comprender cómo la vida puede sobrevivir en condiciones extremas y también nos dan pistas sobre cómo la vida puede existir en otros planetas.
Los extremófilos se dividen en varios grupos según el ambiente en el que pueden sobrevivir. Los termófilos son extremófilos que pueden sobrevivir a altas temperaturas, y se encuentran en ambientes como fuentes termales y geysers. Los psicrofilos son extremófilos que pueden sobrevivir a bajas temperaturas, y se encuentran en ambientes como glaciares y el Ártico. Los halófilos son extremófilos que pueden sobrevivir en ambientes con altas concentraciones de sales, y se encuentran en ambientes como lagos salinos y océanos. Los acidófilos y alcalófilos son extremófilos que pueden sobrevivir en ambientes con altos niveles de acidez o alcalinidad, y se encuentran en ambientes como minas de ácido y pozos de petróleo. Los radiófilos son extremófilos que pueden sobrevivir en ambientes con altos niveles de radiación, y se encuentran en ambientes como centrales nucleares y niveles superiores de la atmósfera.
Los extremófilos han desarrollado mecanismos para adaptarse y sobrevivir en ambientes extremos, y estos mecanismos pueden ser estudiados para desarrollar nuevas tecnologías y productos. Además, los extremófilos también son importantes para la biología evolutiva, ya que nos ayudan a entender cómo la vida puede evolucionar y adaptarse a diferentes ambientes.


¿Cómo era LUCA?
Un equipo del Centro Andaluz de Biología del Desarrollo (CABD) ha publicado un estudio en el que afirman haber descubierto la identidad del organismo conocido como LUCA. Según los científicos, LUCA era una bacteria perteneciente al filo Planctomycetes.
LUCA fue el primer organismo en estrenar, hace miles de millones de años, todos los procesos físicos y químicos necesarios para la vida tal y como la conocemos. Sin embargo, durante mucho tiempo los biólogos han discutido acerca de su verdadera naturaleza, cómo se originó, qué aspecto tenía o dónde vivía.
Como mencionamos arriba los organismos vivos se dividen en dos tipos: procariotas y eucariotas. Los procariotas, como las bacterias, son las formas de vida más simples, mientras que los eucariotas son más complejos, con células más grandes y organizadas en varios compartimentos. La pregunta de cómo se originó uno a partir del otro y cómo evolucionaron es una de las mayores incógnitas de la biología.
Según los investigadores del CABD, -si su hipótesis es cierta-, sus conclusiones supondrían una revolución en la biología evolutiva. El equipo sostiene que de LUCA divergieron los organismos de los otros dos dominios conocidos en el árbol de la vida: Archaea (las arqueas, microorganismos procariotas unicelulares carentes de núcleo pero diferentes de las bacterias) y Eukaryota (los eucariotas, organismos multicelulares, como nosotros mismos).
Arqueas
Las arqueas son un grupo de organismos unicelulares, procariotas, que se caracterizan por ser distintos a las bacterias, aunque comparten muchas similitudes con ellas. Al igual que las bacterias, las arqueas tienen una célula simple, sin núcleo, y carecen de citoesqueleto y organelos membranosos. Sin embargo, las arqueas tienen diferentes tipos de membranas celulares y diferentes sistemas metabólicos, y se encuentran en ambientes extremos, como ambientes con altas concentraciones de sal o altas temperaturas.

Las arqueas se dividen en varios grupos según su estructura y su biología. Algunos grupos de arqueas son metanógenos y producen metano como producto final de la fermentación, mientras que otros son fotosintéticas y producen oxígeno. Algunos grupos de arqueas son termófilos y pueden sobrevivir a altas temperaturas, mientras que otros son halófilos y pueden sobrevivir en ambientes con altas concentraciones de sales.
Las arqueas tienen características únicas que los distingue de las bacterias. Además, las arqueas también son importantes para la biotecnología, ya que algunas arqueas tienen enzimas y mecanismos de resistencia a ambientes extremos que pueden ser utilizados en la producción de productos biológicos y en la bioremediación.
Diferencias entre arqueas y bacterias.
Algunas de las principales diferencias son:
- Membranas celulares: las arqueas tienen una estructura de membrana celular diferente a la de las bacterias. La membrana de las arqueas contiene un tipo de lípido conocido como esfingolípido, mientras que las bacterias tienen un tipo de lípido conocido como esfingomielina.
- Sistemas metabólicos: las arqueas tienen una variedad de sistemas metabólicos diferentes a los de las bacterias. Algunas arqueas son metanógenas y producen metano como producto final de la fermentación, mientras que otras son fotosintéticas y producen oxígeno.
- Ambientes: las arqueas son capaces de vivir en ambientes extremos, como ambientes con altas concentraciones de sal o altas temperaturas, mientras que las bacterias son más comunes en ambientes más templados.
- Genética: las arqueas tienen un sistema de codificación de aminoácidos diferente al de las bacterias.
- Filogenesia: las arqueas y las bacterias pertenecen a diferentes filos, las arqueas pertenecen al filo arquea y las bacterias al filo bacterias, esto indica que tienen una evolución diferente.
Las Arqueas de Asgard, LUCA el viajero espacial.
Las arqueas de Asgard son un grupo de arqueas recientemente descubiertas que se caracterizan por tener un sistema de codificación de aminoácidos y una estructura de membrana celular diferente a las arqueas conocidas previamente. Su nombre se deriva de la mitología nórdica, ya que se cree que estas arqueas vienen de un ambiente extraterrestre.
Las arqueas de Asgard fueron descubiertas en ambientes extremos de la Tierra, como ambientes con altas concentraciones de metales y altas temperaturas, y se cree que pueden haber llegado a la Tierra en un cometa o un meteorito. Se les ha encontrado en ambientes como minas de hierro y pozos de petróleo caliente.
Las arqueas de Asgard tienen un sistema de codificación de aminoácidos único, y se cree que pueden tener un origen extraterrestre ya que sus características no se encuentran en los organismos conocidos en la tierra. Aunque se ha propuesto que podrían tener un origen extraterrestre, no hay suficiente evidencia científica para confirmarlo, y se está investigando más sobre estos organismos.
Un equipo de investigadores del Centro Andaluz de Biología del Desarrollo (CABD) propone un cambio radical en las relaciones entre los tres dominios del árbol de la vida. Según sus investigaciones, las arqueas, las bacterias y los eucariotas descienden todos de una sola rama, las bacterias Planctomycetes. Esta propuesta se basa en características de estas bacterias y en datos recientes de filogenia de proteínas ribosómicas publicadas por Tom Cavalier Smith.
Carl Woese descubrió las arqueas a finales del siglo pasado, un tercer dominio de vida dentro de los procariotas. Las arqueas se parecen a las bacterias pero son más cercanas a los eucariotas en términos de organización, mantenimiento y expresión de su material genético.
Recientemente, se ha descubierto un grupo de arqueas, Asgard, los organismos procariotas más cercanos a los eucariotas. El punto de vista más reciente defiende que los eucariotas han evolucionado desde una arquea que ha incorporado una bacteria.
El equipo del CABD ha dedicado más de diez años de estudio a las bacterias del filo Planctomycetes. Estas bacterias tienen características que no se encuentran típicamente en bacterias pero que en ocasiones están asociadas con los organismos de los otros dos dominios, Archaea y Eukaryota. Entre estas características hay que destacar su desarrollado sistema de endomembranas, su ADN condensado, la presencia de esterol en la membrana -en algunos- o de proteínas de revestimiento membrana, entre otras.
Los investigadores proponen que estas bacterias son nuestros ancestros más antiguos y que solo hay un dominio ancestral, Bacteria. A partir de estas características y del conocimiento publicado, se propone que estas bacterias han divergido y desarrollado características diferentes, dando lugar a los otros dos dominios, Archaea y Eukaryota.
Este cambio en las relaciones evolutivas entre los tres dominios tiene importantes implicaciones para comprender mejor nuestra evolución. Los investigadores reivindican la necesidad de explorar la biodiversidad entre las bacterias Planctomycetes y el ancestro común de eucariotas y arqueas para poder entender mejor nuestra evolución.”





